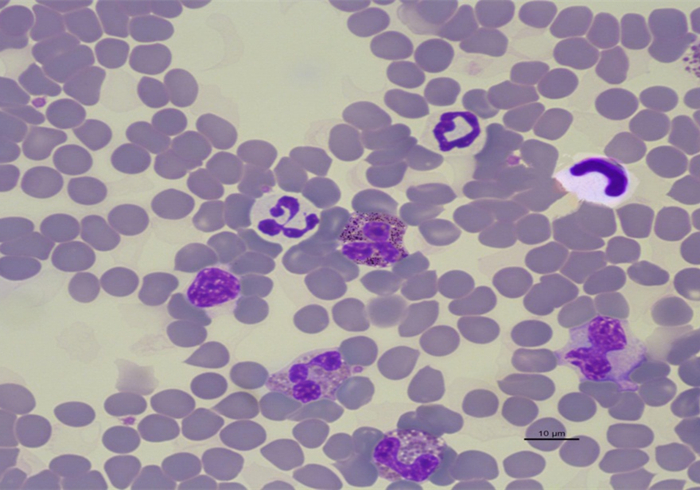
爱猫体检后发现白细胞增多就是有疾病？主因是猫压力过大
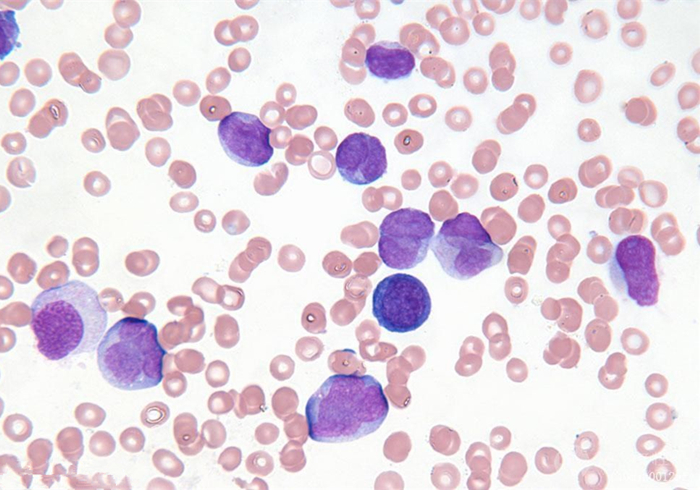
爱猫体检后发现白细胞增多就是有疾病？主因是猫压力过大

一直以来,我们对于某种疾病的治疗总是很上心,可是却因为各种各样的原因,却忽略了常规的体检预防。
当然,这种情况在近几年来渐渐出现了改观,不仅我们人类会主动去医院进行全身体检,一些养猫的铲屎官还会带着自家的猫咪去医院里来一个全身检查。
说起来体检这种事,真是让人心情忐忑。无论是在体检进行的过程中,还是在最后报告单出来的时候,都会让人为自己或者为猫咪捏一把汗,你说这要是得了什么不好的病,该怎么办呀?

会有这样的担心其实也是正常的,可是担心过了头也是会闹出不少笑话。比如之前我陪一个朋友带着他家的猫咪去医院做体检,结果,最后体检报告出来的时候,这个一米八几的大男人竟然腿都抖了。
我忙问这是怎么了?他跟我说,他看到体检报告上,猫咪的白细胞和中粒细胞的数量升高,只怕是得了什么炎症了。

当时我看了一眼体检报告,觉得情况还不算太严重,本想宽慰几句,没想到朋友竟然抄起体检报告,直接奔向了医生的办公室。等到后来我气喘吁吁地追到办公室时,居然发现朋友正一脸乖巧地坐在板凳上听医生敦敦教诲,猫咪啊其实一点事都没有。
猫咪的白细胞数量升高就是得了炎症?就需要赶紧消炎?专业兽医告诉你,别慌,这当中还是有着不少区别的。
根据兽医的说法,猫咪白细胞升高或中粒细胞升高,一般分为以下三种情况。
一、压力性白细胞升高。
这种情况下,猫咪其实并没有生病,只是由于某种原因导致心理方面出现了一定的压力或紧张。比如猫咪很有可能是被铲屎官带到医院后,面对陌生的环境和陌生的人类而产生了压力。

猫咪产生了一定压力后,身体就会分泌相应的激素,并启动相应的机制。而这个机制和应对疾病入侵的机制异曲同工。而在体检报告上,就会直接表现为白细胞和中粒细胞的增加。
其实铲屎官想要判断这一现象也很简单,压力性白细胞升高主要表现为成熟中粒细胞上升,不过这种上升,一般不会超过上限的一倍。与中粒细胞上升相伴的是猫咪的淋巴细胞下降,这也是压力性白细胞上升的主要特征。

二、生理性白细胞升高。
如果说压力性白细胞升高是由于猫咪对抗压力而分泌激素而引起的,那么生理性白细胞升高则是由于猫咪为了对抗大量的压力而分泌大量的激素而引起的。说白了,前者是猫咪有点慌引起的,而后者则是猫咪很慌引起的。
虽然都是由于压力和紧张所造成的结果,但生理性白细胞增高与压力性白细胞增高的表现完全不同。铲屎官可以从体检报告当中明显的看出猫咪的白细胞上升,中粒细胞也有一定程度的上升,并且HCT和血小板升高。
由于猫咪此时过度紧张,身体就会将其判定为疾病大规模的入侵,所以脾脏就会释放淋巴细胞,从而在体检报告上就会显示为淋巴细胞上升,这也是判断生理性白细胞上升和压力性白细胞上升的一个重要区别。除此之外,猫咪还有一定的几率出现嗜碱性细胞和嗜酸性粒细胞的上升。

三、急性炎症。
看到急性炎症三个字,相信大家都明白,这种情况不比前面两种情况,这是猫咪真的出问题了。
急性炎症的白细胞上升和前面两种情况的白细胞上升有所不同。前面两种情况只不过是猫咪的身体在压力的影响下所激发的防御机制,相当于只是一个简单的试探,白细胞升高的数量不会很多。

但猫咪如果得了急性炎症,疾病的入侵可就是来真的了,所以白细胞就会源源不断的增加,在体检报告上的表现就为急剧上升。与白细胞相应的,猫咪的中粒细胞作为身体卫士自然也会倾巢出动,基本上可以达到平常上限的两倍或以上。
而炎症的发生,也有可能会使得猫咪的单核细胞升高以及淋巴细胞的被消灭。

以上三种情况都会带来猫咪的白细胞增加,但凡事关千万不要以为这就结束了,最后兽医告诉我们,还应该注意另外一种情况,也就是猫咪白细胞的急剧下降。
猫咪白细胞升高固然会代表疾病发生的可能,但猫咪的白细胞急剧下降则有可能代表疾病的恶化。
这就好比是打仗,白细胞和中粒细胞作为身体卫士数量源源不断的增多,至少证明疾病还没有彻底入侵。但是,如果己方的战士全部被消灭或死伤惨重,那就说明敌人实在过于强大,身体已经扛不住了。
所以,当猫咪出现重度炎症或身体恶化时,白细胞和中粒细胞在体检报告的表现上就是急剧下降,并且,有可能伴随着淋巴细胞的急剧下降。
说了这么多,相信大家对于猫咪白细胞升高这件事,有了一个大致的了解。但我也知道,像白细胞、淋巴细胞、中粒细胞这样的指标一般人是很难一下子理清楚,并且我们判断升高总要有一个基本的参考数据吧。
嘿嘿,别急,下面我就给大家提供一份猫咪以及狗狗的血常规检查的正常标准作为参考。

当然我还是要提醒一句的是,以上的内容只不过是想告诉各位铲屎官要多多了解猫咪身体的各项指标以及相应的疾病知识,这样才可以辨别其中的区别,避免像我朋友自己吓自己的情况出现。
各位铲屎官拿到猫咪的体检报告表示,可以先自行梳理一遍,如果对其中存有疑惑也可以去咨询医生,毕竟这样不仅能够确保万无一失,还能够学习一些新知识不是?
参考文献:[1]王姜维, 曹燕, 陈艳云,等. 猫嗜酸性粒细胞性硬化性纤维增生病例报告[J]. 中国兽医杂志, 2016, 52(4):96-98.
[2]NielsC.Pedersen, 魏泓. 猫嗜T淋巴细胞病毒的分离[J]. 实验动物与比较医学, 1989(2):129-129.
[3]佚名. 体检? 说了多少年了 铲屎官们从未提上过日程[J]. 宠物世界, 2019(4):52-53.
[4]张华, 侯绍华. 血常规检查在犬猫疾病诊断中的应用[J]. 中国动物检疫, 2009, 26(3):55-56.

#猫咪大明星##2019生机大会#